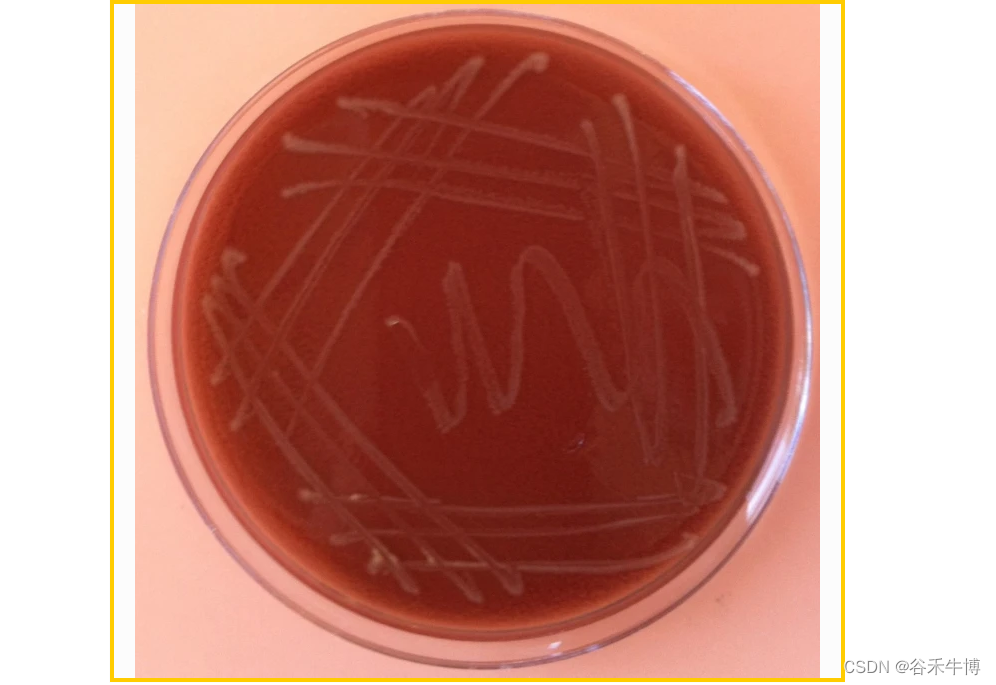

谷禾健康

嗜血杆菌属(Haemophilus spp) 是变形菌门,小的、多形性、不活动、无孢子的革兰氏阴性杆菌或球杆菌。它们是需氧的和兼性厌氧的。主要寄居于人和动物的咽喉和口腔黏膜,少数见于生殖道,不过很多时候在粪便中也能检出。该病原菌能引起原发性化脓性感染及严重的继发感染。
嗜血杆菌属(Haemophilus)是一组细菌的名称。它们会引起不同类型的疾病,涉及呼吸、骨骼和关节以及神经系统。嗜血杆菌属的丰度与多种疾病和健康状态有关。例如,嗜血杆菌属在多发性硬化症、结直肠癌等患者中的丰度增加。

Photograph by David M. Phillips
嗜血杆菌属的过度生长与一些炎症性肠道疾病、肠道肿瘤和代谢性疾病的发生有关。嗜血杆菌属的存在可以引起肠道炎症反应,导致肠道黏膜的损伤和疾病的发展。
其次,嗜血杆菌属与一些疾病相关的菌群存在相互作用。例如,在某些研究中发现,嗜血杆菌属与肠道菌群中的某些菌属(如Prevotella、Roseburia、Subdoligranulum和Dorea)呈负相关。此外,嗜血杆菌属可能通过影响肠道菌群的代谢产物来调节疾病的发生和发展。例如,嗜血杆菌属与肠道代谢物(如丙酸和戊酸)的浓度呈负相关。
嗜血杆菌属包括许多可引起多种感染的菌种,但它们具有共同的形态,并且在生长过程中需要血源性因子,因此该属得名。
此外,嗜血杆菌属里比较受关注的是流感嗜血杆菌(Haemophilus influenzae)。
已知荚膜类的乙型流感嗜血杆菌(或是b型流感嗜血杆菌,简称HiB)是毒性的主因之一,通常会导致 2 岁以下儿童的血流侵入和脑膜炎,偶而地它会引致蜂窝组织炎、骨髓炎及关节感染。Hib 结合疫苗是减少嗜血杆菌相关疾病发病率的重要措施。对于住院患者,联合使用氨苄西林和氯霉素或单一头孢菌素如头孢呋辛、头孢噻肟或头孢曲松是有效的治疗方法。
本文一起来了解一下嗜血杆菌属的生物学特性,代谢途径,和其他菌群相互作用,与疾病之间的关联,耐药性和抗生素治疗等,嗜血杆菌属的研究对于理解呼吸道感染的发病机制、疫苗研发和公共卫生具有重要意义。
01
关于嗜血杆菌属
✓
嗜血杆菌属(Haemophilus)是一种人体常见的细菌属,它可以在人体的口腔、呼吸道和消化道中寄生。属于变形菌门,巴斯德氏菌科,该科还包含另外两个属:放线杆菌属和巴斯德氏菌属。
属于该科的细菌是小型(1 × 0.3 μm)、不形成孢子的球杆菌,具有苛刻的生长要求,通常需要补充培养基才能进行体外分离。
大多数嗜血杆菌属需要两种补充剂——因子 X(血红素)和 V(烟酰胺腺嘌呤二核苷酸,NAD)——才能在人工培养基上有氧生长。
- X 因子可由包括原卟啉在内的含铁色素提供,对于参与细菌电子传递链的过氧化氢酶、过氧化物酶和细胞色素至关重要
- V 因子可由 NAD 或 NAD磷酸盐提供,或作为烟酰胺核苷提供
- X 因子和 V 因子均存在于血液中;然而,由于存在不耐热的 V 因子抑制剂,因此必须先将血液加热,然后再添加到培养基中(形成巧克力琼脂)才能成功分离嗜血杆菌
巧克力琼脂平板上生长的流感嗜血杆菌菌落
doi:10.1186/2001-1326-1-10
但是注意,当细菌在实验室培养基上生长时,流感嗜血杆菌(Haemophilus influenzae)的生存力会迅速下降,通过未知的机制在 48 至 72 小时内变得不可培养。因此,如果需要,应在嗜血杆菌菌株在固体培养基上以离散菌落形式出现后立即对其进行永久储存。
▼
毒力因子
- 荚膜抗原(在胶囊化菌株中):抗吞噬细胞
- 粘附素蛋白(例如HMW1、HMW2)介导与气道中的人上皮细胞的附着。
- 菌毛和主要外膜蛋白 P2:将含有唾液酸的部分结合到上皮细胞表面。
不可分型流感嗜血杆菌是定植于人类呼吸道的主要病原体。细菌在哺乳动物组织上的粘附是由菌毛介导的,被认为是定植的重要前体,而上呼吸道感染与菌毛的存在有关。这些微生物引起的呼吸道感染包括鼻窦炎、中耳炎、急性气管支气管炎和肺炎。
- IgA1 蛋白酶:在铰链区裂解免疫球蛋白 A,防止凝集并机械消除病原体
- 相变:外表面蛋白质被修饰以适应宿主环境的变化。
- 体内生物膜的产生:在急性中耳炎的发病机制中尤其重要。
急性中耳炎是最常见的儿科细菌感染,在 5 岁之前的某个时期影响多达 75% 的儿童。肺炎链球菌和流感嗜血杆菌(主要是 NTHi)造成了高达 80% 的细菌急性中耳炎。
从儿童或成人急性感染的鼻窦或婴儿和幼儿受感染的鼓膜后面吸出的化脓性物质通常含有无法分型的流感嗜血杆菌。
外膜蛋白谱研究表明,中耳和鼻咽分离株是相同的,这支持了咽鼓管定植以及随后的阻塞和感染可能是其原因的观点。中耳炎的反复发作是由不同的菌株引起的。每次感染可能与针对独特表面蛋白的抗体的出现有关。随着年龄的增长,中耳炎的发病率逐渐降低,部分原因是解剖结构的变化,部分原因是对流感嗜血杆菌的免疫力。
▼
分类
巴斯德氏菌科的几个 16S rRNA 序列特征已得到证实,但这些特征都不是目前定义的嗜血杆菌属所特有的。DNA 的 mol% G + C 为:37–44。
模式种:
- 流感嗜血杆菌(Haemophilus influenzae)
其他研究的菌种包括:
- Haemophilus aegyptius
- Haemophilus galanarium
- Haemophilus haemoglobinophilus
- Haemophilus haemolyticus
- Haemophilus influenzae-murium
- Haemophilus paracuniculus
- Haemophilus parahaemolyticus
- Haemophilus parainfluenzae
- Haemophilus paraphrohaemolyticus
- Haemophilus pittmaniae
- Haemophilus quentini
- Haemophilus simiae
- Haemophilus sp.
- Haemophilus sp. oral taxon 035
- Haemophilus sp. oral taxon 036
- Haemophilus sputorum
- Haemophilus taxon C
- Haemophilus ducreyi
- Haemophilus parasuis
其中以下菌种有致病性,但是致病机理和其他菌种的致病性还需要更多研究确定。
- Haemophilus paraphrohaemolyticus(副溶血性嗜血杆菌 )
- Haemophilus parahaemolyticus(副溶血嗜血杆菌)
- Haemophilus haemolyticus(溶血嗜血杆菌)
- Haemophilus aegyptius(埃及嗜血杆菌)
- Haemophilus influenzae(流感嗜血杆菌)
- Haemophilus parainfluenzae(副流感嗜血杆菌)
- Haemophilus ducreyi(杜克雷嗜血杆菌)
- Haemophilus parasuis(副猪嗜血杆菌)
- Haemophilus pittmaniae
其中Haemophilus ducreyi和Haemophilus aegyptius容易形成生物膜。
注:许多细菌可以形成称为生物膜的聚集结构。生物膜中的生物通常表现出与处于个体状态或浮游状态的同一生物基本不同的特性。 聚集到生物膜中的细菌可以传达有关种群大小和代谢状态的信息。 这种类型的通信称为群体感应,通过产生称为自动诱导剂或信息素的小分子来进行操作。
群体感应分子【最常见的是肽或酰化高丝氨酸内酯(AHL;特殊的信号化学物质)】的浓度与生物膜中相同或不同物种的细菌数量有关,有助于协调生物膜的行为。
扩展阅读:
细菌如何交流和占地盘——细菌的群体感应和生物膜
“微观系统网”——微生物生物膜与健康和疾病
一文了解 | 革兰氏阳性和阴性菌区别,致病差异,针对用药
▼
代谢
Haemophilus生长最佳温度为 35–37°C。氧化酶和过氧化氢酶反应因菌株而异。化学有机营养型。所有物种都可以发酵碳水化合物,葡萄糖代谢产生乙酸、乳酸和琥珀酸作为最终产物。作为专性寄生存在于人类和多种动物的粘膜上。

KEGG 途径还包括:
- 2-氧代羧酸代谢
- 丙氨酸、天冬氨酸和谷氨酸代谢
- 氨基糖和核苷酸糖代谢
- 氨酰-tRNA生物合成
- 氨基苯甲酸酯降解
- 精氨酸和脯氨酸代谢
- 精氨酸生物合成
- 抗坏血酸和丙二酸代谢
- 细菌趋化性
- 碱基切除修复
- 氨基酸的生物合成
- 抗生素的生物合成
- 次生代谢物的生物合成
- 不饱和脂肪酸的生物合成
- 生物素代谢
- 丁酸代谢
- C5-支链二元酸代谢
- 碳青霉烯生物合成
- 碳代谢
- 阳离子抗菌肽 (CAMP) 耐药性
- 氯烷和氯烯烃降解
- 柠檬酸循环(TCA循环)
- 氰基氨基酸代谢
- 半胱氨酸和蛋氨酸代谢
- D-丙氨酸代谢
- D-谷氨酰胺和 D-谷氨酸代谢
- DNA复制
- 芳香族化合物的降解
- 脂肪酸生物合成
- 脂肪酸降解
- 脂肪酸代谢
- 叶酸生物合成
- 果糖和甘露糖代谢
- 半乳糖代谢
- 谷胱甘肽代谢
- 甘油脂代谢
- 甘油磷脂代谢
- 甘氨酸、丝氨酸和苏氨酸代谢
- 糖酵解/糖异生
- 乙醛酸和二羧酸代谢
- 组氨酸代谢
- 同源重组
- 磷酸肌醇代谢
- 胰岛素抵抗
- 硫辛酸代谢
- 脂多糖生物合成
- 赖氨酸生物合成
- 赖氨酸降解
- 甲烷代谢
- 萘降解
- 烟酸和烟酰胺代谢
- 氮代谢
- 泛酸和 CoA 生物合成
- 戊糖和葡萄糖醛酸相互转化
- 磷酸戊糖途径
- 肽聚糖生物合成
- 苯丙氨酸代谢
- 苯丙氨酸、酪氨酸和色氨酸生物合成
- 磷酸转移酶系统(PTS)
- 卟啉和叶绿素代谢
- 嘌呤代谢
- 嘧啶代谢
- RNA降解
- RNA聚合酶
- 核黄素代谢
- 硒化合物代谢
- 淀粉和蔗糖代谢
- 链霉素生物合成
- 硫代谢
- 萜类骨架生物合成
- 色氨酸代谢
- 酪氨酸代谢
- 泛醌和其他萜醌生物合成
- 缬氨酸、亮氨酸和异亮氨酸生物合成
- 缬氨酸、亮氨酸和异亮氨酸降解
- 万古霉素耐药性
- 维生素B6代谢
- β-内酰胺抗性
▼
与其他细菌的互作
与肺炎链球菌的相互关系
嗜血杆菌与肺炎链球菌都能在人类的上呼吸系统中发现。一项有关它们之间的竞争研究指出,在培养基内,肺炎链球菌能以过氧化氢攻击流感嗜血杆菌,及能排除在表面流感嗜血杆菌生存所需的分子。
当两种细菌一同在鼻腔内时,两星期之内,只有流感嗜血杆菌能够生存。当两种细菌分别地放在鼻腔内时,两者皆能生存。使实验鼠的上呼吸组织暴露于两种细菌时,发现有格外大量的中性粒细胞。当实验鼠只是暴露于其中一种细菌时,则不会出现这些细胞。
实验显示,接触过嗜血杆菌死菌的中性粒细胞对肺炎链球菌会强烈攻击,而未接触过流感嗜血杆菌死菌的中性粒细胞的这种攻击则较不会这么强烈。
接触流感嗜血杆菌死菌,却不会对流感嗜血杆菌活菌有所影响。这种现象有两种可能性:
(1)当嗜血杆菌被肺炎链球菌攻击时,引发了免疫系统攻击肺炎链球菌。
(2)两种细菌的结合引发了只有其中一种细菌存在所不会引发的免疫系统警报。
至于为何流感嗜血杆菌会不受免疫系统的影响则不得而知。
与其他菌的互作
在一些研究中发现,普雷沃氏菌属(Prevotella)的相对丰度与Haemophilus的相对丰度呈负相关,这种互作可能对疾病的发展和治疗产生影响。
Haemophilus与厚壁菌门中的Roseburia、Subdoligranulum和Dorea之间存在负相关关系。这意味着Haemophilus的增加可能会导致这些厚壁菌门的特定菌属减少。
而比较惊讶的是在一些研究中发现,Haemophilus的相对丰度与Akkermansia的相对丰度呈正相关,这种互作可能对肥胖和代谢性疾病的发展产生影响,但是该结论还需要在更多的研究中验证。
在一些疾病中Haemophilus和拟杆菌属的相对丰度在一些疾病中呈现出相互竞争的趋势,这种互作可能对肠道微生物群的稳态和健康产生影响。
02
常见菌种
✓
▼
流感嗜血杆菌
Haemophilus influenzae
听名字可能会认为该菌是引起流感的元凶,但并不是,是因为流感嗜血杆菌是1892年被德国的一位细菌学家理查德.法伊弗医生在一位流感病人身上分离得到的,因此,此后一段时间流感嗜血杆菌也被认为是引起流行性感冒的病原体,直到1933年流感病毒被分离出来。1995年,第一个活体物种嗜血流感菌(Haemophilus influenzae,1.8Mb)的基因组测序完成。
分 类
流感嗜血杆菌是嗜血杆菌属主要病原体,它可分为有荚膜或可分型菌株,根据荚膜多糖的抗原结构,有七种类型(a至f,包括e')和无荚膜或不可分型菌株。没有荚膜的菌株则较少侵略性,但它们能诱发炎症而产生其他病症,如会厌炎(主要症状有剧烈的喉痛、吞咽困难和呼吸困难等)。
注:荚膜是细菌比较常见的结构,是位于细胞壁表面的一种粘液型物质,也是重要的致病因子。荚膜可以帮助细菌抵抗人体免疫系统的吞噬和补体介导的溶菌作用,就如细菌的“防弹衣”或“盔甲”,人体的免疫系统原本可以很轻松的击毙细菌,而一旦细菌有了“防弹装备“”,它们就更容易存活下来。
荚膜多糖进化的一个可能的原因是,与缺乏荚膜的多糖相比,它们赋予细胞了一定的抗干燥性。这可能在宿主到宿主的传播过程中提供健康益处,这是细菌生命周期的关键部分。
流感嗜血杆菌可正常寄居于我们的上呼吸道,当抵抗力下降、免疫功能较差时,才会引起呼吸道感染。因此,婴幼儿、学龄期儿童、孕妇、老人等就成为了流感嗜血杆菌的主要攻击目标。作为儿童临床中常见的条件致病菌之一,是引起儿童社区获得性肺炎仅次于肺炎链球菌的致病菌。
人体内的常居部位及携带率
Haemophilus influenzae通常可以寄居在我们的呼吸道、眼结膜和阴道黏膜上。湿润的鼻咽黏膜就是它比较喜欢的栖息场所。
人群鼻咽部的Haemophilus influenzae的携带率受到了年龄、生理因素、人群密集程度、社会经济因素以及疫苗接种率等因素的影响。在未开展Haemophilus influenzae疫苗接种之前,发达国家约有3%~5%的健康学龄儿童是无症状Haemophilus influenzae的携带者。
它也是主要在上呼吸道发现的专性人类共生菌。最近临床从血液、痰液、肺泡灌洗液及阴道分泌物等各类临床标本中均有分离到Haemophilus influenzae,而且我们在粪便高通量测序检测实践中也检出Haemophilus influenzae,表明感染明显增多。
该菌作为一种苛养菌,其生长需要V和X因子,在培养中稍不留神容易漏检。临床标本中分离出的流感嗜血杆菌形态多种多样,从球杆菌到长丝状杆菌。这种不一致的形态和经常变化的染色(尤其是革兰氏染色中的沙弗宁)可能会导致临床微生物实验室的诊断混乱。
临床感染
流感嗜血杆菌(Haemophilus influenzae)可以导致多种类型的临床感染。
该菌可在局部蔓延引起非侵袭性疾病,如无菌血症的肺炎、中耳炎、鼻窦炎和结膜炎;
还可导致更为严重的侵袭性疾病,如脑膜炎、败血症、有菌血症的肺炎、会厌炎、脓性关节炎、心包炎、骨髓炎、软组织化脓及蜂窝组织炎等。
感染率
来自我国的研究发现,1990-1992 年中国合肥地区 Hib 脑膜炎占小儿细菌性脑膜炎的 51.7%。
复旦大学附属儿科医院对上海市 2000-2005 年 266 例临床诊断为细菌性脑膜炎的患儿进行致病菌抗原检测,Haemophilus influenzae阳性率为 15.4% 。5岁以下Haemophilus influenzae脑膜炎患儿的病死率为9.7%,存活患儿中21.4%的有精神和神经系统后遗症,主要包括硬膜下积液、听力和/或智力障碍、轻度瘫痪等。
感染宿主
流感嗜血杆菌非常适合人类宿主,并且没有其他已知的自然感染宿主。
据推测,大约一万年前,人类从“狩猎采集者”的生活过渡到以农业为基础的社区生活之后,就一直接触到一系列新型细菌。那时,人类开始与牲畜近距离生活,然后可能获得了嗜血杆菌的共同祖先,它也是其他几种嗜血杆菌的祖先。宿主特异性细菌,如放线杆菌和巴斯德氏菌,现在发现于牛和猪等家畜中。
代 谢
流感嗜血杆菌Rd菌株的全基因组序列极大地增加了我们对该细菌生物学的了解。嗜血杆菌似乎在代谢上适应了富氮、微厌氧的环境。编码三羧酸 (TCA) 循环中的三种酶(乌头酸酶、柠檬酸合成酶和异柠檬酸脱氢酶)的基因缺失。这解释了在特定的实验室培养基中生长期间需要通过 α-酮戊二酸进入 TCA 循环的谷氨酸。与大肠杆菌相比,嗜血杆菌中的双组分系统较少(总共六个)(>40);双组分系统将特定的环境信号(例如 pH 值、渗透压和阳离子浓度的变化)转换为细菌细胞内程序化的协调反应。显然,嗜血杆菌适应环境变化的机制与肠杆菌科等细菌的机制不同。
判别:流感嗜血杆菌
涂片镜检:采集肺炎患者的痰,脑膜炎患者的脑脊液或者患者感染部位的分泌物等,经革兰染色后显微镜下观察,如查见上述形态图中的红色细小杆菌将有助于诊断。
细菌培养:是诊断流感嗜血杆菌感染的金标准,但对于呼吸道标本,需要医生结合临床症状、标本质量等因素综合考虑是否为感染。
还可以通过检测血清中流感嗜血杆菌抗原或抗体,咽拭子、脑脊液,粪便等标本中流感嗜血杆菌基因测序来进行快速诊断。
传染源
虽然只有少部分携带者会发展为临床病例,但携带者是流感嗜血杆菌的主要传染源。
传播途径
主要经呼吸道飞沫传播,接触患者的呼吸道分泌物也可感染。新生儿可因吸入羊水或出生时接触产道分泌物而感染。
易感人群
该细菌的目标人群是免疫抑制/免疫抑制患者、脾切除患者和未接种疫苗的患者。此外,Haemophilus influenzae引起的疾病与年龄密切相关, 在未引入疫苗的地区,有超过60%的侵袭性疾病发生在1岁之前,主要集中在6-11月月龄的婴儿。而5岁及以上的儿童就很少发生由Haemophilus influenzae引起的侵袭性疾病了(少于10%)。由此婴幼儿是我们要重点关注的人群。
没有特定症状可以将流感嗜血杆菌肺炎与其他细菌区分开来。
可以怀疑 3 个月至 3 岁的儿童患有流感嗜血杆菌肺炎;而且疫苗接种状态不存在或不完整,最近使用抗生素或使抗生素后 48-72 小时内发烧未消退。
它不仅是肺炎的常见原因,而且会引起急性中耳炎,我们还应该怀疑上述相同经历的患者,特别是那些患有中耳炎并可能影响多个家庭成员的结膜炎的患者。
治 疗
流感嗜血杆菌感染需用抗生素治疗。使用哪种抗生素取决于感染的严重程度、感染部位以及药敏结果。
如果儿童出现严重感染,应将他们收入医院并予以隔离,以防止其他人接触到他们排放至空气中的飞沫(称作呼吸道隔离),隔离应持续至开始抗生素治疗后24小时。
脑膜炎必须尽早治疗。可静脉输注头孢曲松或头孢噻肟治疗流感嗜血杆菌脑膜炎。服用皮质激素有助于预防脑部损害。
会厌炎也必须尽早治疗。患者可能需要辅助呼吸。可能需要建立人工气道,如呼吸管插管,罕见情况下可能需要开放气道(称为气管切开术)。应给予一种抗生素,如头孢曲松、头孢噻肟或头孢呋辛。
由流感嗜血杆菌引起的其它感染可使用各种口服抗生素治疗。它们包括阿莫西林/克拉维酸钾、阿奇霉素、头孢菌素类、氟喹诺酮类等。
▼
埃及嗜血杆菌
Haemophilus aegyptius
埃及嗜血杆菌(Haemophilus aegyptius)值得特别提及,因为它可以引起类似脑膜炎球菌的疾病。在南美洲,这种微生物是导致巴西紫癜的原因。这种灾难性疾病在 10 岁以下儿童中尤为突出,通常以超急性结膜炎开始,随后在 3 至 5 天内出现发烧。48 小时内会出现播散性紫癜、低血压休克和死亡。
分子研究表明,引起巴西紫癜热的所有分离株都具有遗传相关性。最初,所有报告的病例都来自巴西圣保罗和邻近的巴拉那州,但其他地区出现了新菌株,引发了人们对该疾病可能在全球范围内传播的担忧。
致病性埃及嗜血杆菌的基因组大于非致病性菌株的基因组。细菌物种之间频繁的基因交换已被证明是这种遗传添加的基础。埃及嗜血杆菌个别菌株还可引起急性结膜炎,俗称“红眼病”,有高度传染性。
▼
杜克雷嗜血杆菌
Haemophilus ducreyi
杜克雷嗜血杆菌(Haemophilus ducreyi)是一种高度传染性的革兰氏阴性细菌,可通过性传播。它是性病感染的原因:软下疳。杜克雷嗜血杆菌在女性中仅引起轻微症状,而在男性中,下疳却极其疼痛。它会导致快速发展的病变,以与生殖器区域剧烈瘙痒相关的深度溃疡的形式出现。显微镜检查发现杜克雷嗜血杆菌。
▼
副流感嗜血杆菌
Haemophilus parainfluenzae
副流感嗜血杆菌是一种粘膜寄生菌,特别存在于口咽、泌尿生殖系统和直肠中。这是人类最常见的嗜血杆菌属,因为它占咽部菌群的 10%,有时在唾液中大量存在。这种病原体可引起呼吸道和耳鼻喉感染,特别是在免疫功能低下的人群中。副流感嗜血杆菌还可引起突发性心内膜炎。
03
肠道嗜血杆菌的健康相关
✓
肠道微生物群中大量存在的嗜血杆菌是否会对健康产生积极或消极影响仍然未知。据报道,多发性硬化症、结直肠癌患者的嗜血杆菌丰度增加,并且也与腺瘤患者的结直肠癌发展相关。相反,嗜血杆菌属减少与 II 型糖尿病的发展有关,并且个别 II 型糖尿病的嗜血杆菌属的完全耗尽。
▼
类风湿性关节炎
研究发现,类风湿性关节炎(RA)患者口腔和肠道中的Haemophilus属菌群相对丰度较低。在类风湿性关节炎患者中,Haemophilus的相对丰度降低与类风湿性关节炎特异性自身抗体(抗环瓜氨酸肽)和类风湿因子的水平降低相关。这表明Haemophilus可能在类风湿性关节炎的发病和病理过程中发挥一定的作用。
注:抗环瓜氨酸肽抗体是以合成的环化瓜氨酸多肽(CCP)为抗原的自身抗体,对类风湿关节炎(RA)具有较高的敏感性和特异性,是RA早期诊断的一个高度特异指标。
类风湿性关节炎患者的唾液、牙菌斑和粪便样本中嗜血杆菌种类减少,类风湿性关节炎治疗后部分正常化。
肠道和口腔环境极其复杂,这些环境中的微生物群起着至关重要的作用。在维持体内平衡中发挥重要作用。据报道,随着肠道微生物群与免疫系统的接触减少,过敏性以及自身免疫性和炎症性疾病的发病率和患病率显著增加。
Haemophilus与炎症反应的调节
Haemophilus可能通过调节免疫反应参与类风湿性关节炎的发展。研究发现,Haemophilus属菌群的降低与炎症标志物的水平降低相关。例如,嗜血杆菌属与 C 反应蛋白(急性炎症标志物)呈负相关。
Haemophilus与肠道菌群失调的关联
类风湿性关节炎患者肠道菌群失调可能与Haemophilus的降低有关。肠道菌群失调已被认为是类风湿性关节炎发展的一个重要因素。Haemophilus与自身抗体的水平相关:Haemophilus的降低与类风湿性关节炎患者自身抗体水平的降低相关。自身抗体在类风湿性关节炎的发病和病情进展中起着重要作用。
▼
结直肠癌
Haemophilus是一种与结直肠癌发病和发展相关的细菌。以下是Haemophilus参与结直肠癌的发病和发展的机制和关联线索:
肠道菌群失调
Haemophilus的丰度在结直肠癌患者中较高,与肠道菌群的失调有关。肠道菌群的失调可能导致炎症反应和免疫系统的异常,从而促进结直肠癌的发展。
炎症反应
Haemophilus可能通过引起炎症反应来促进结直肠癌的发展。炎症反应可以导致细胞损伤和DNA损伤,进而增加癌症的发生风险。
免疫调节
Haemophilus可能通过影响免疫系统的功能来参与结直肠癌的发展。它可能影响肠道免疫细胞的活性和功能,从而干扰对癌细胞的清除和抑制。
其他细菌的相互作用
Haemophilus可能与其他细菌相互作用,共同参与结直肠癌的发展。例如,与口腔菌群中的Fusobacterium相互作用可能导致肠道炎症和癌症的发展。
▼
多发性硬化
多项研究报道了肠道内Haemophilus参与了多发性硬化(MS)的发病和发展。Haemophilus可能通过分子模仿来激活自身免疫T细胞,从而导致多发性硬化的发展。研究发现,Haemophilus的蛋白质结构与多发性硬化相关的蛋白质结构相似,可能引发自身免疫反应。此外,Haemophilus的丰度变化与肠道菌群失调有关。肠道菌群失调已被证明与多发性硬化的发展和进展有关。
多发性硬化症 (MS) 是一种中枢神经系统 (CNS) 脱髓鞘疾病。遗传和环境因素,如细菌或病毒感染,涉及其多因素病因。在推定与该疾病相关的病毒因子中,EB 病毒 (EBV) 已被多次报道,流感嗜血杆菌被描述为多发性硬化症可能的细菌触发剂。尽管多发性硬化症的病因和发病机制尚未完全阐明,但人们普遍认为,针对髓磷脂和其他相关蛋白的 T 细胞介导的炎症过程起着至关重要的作用,同时 B 细胞也可能发挥作用。
在多发性硬化症中,肠道内的甲烷短杆菌属、假单胞菌属、支原菌属、嗜血杆菌属、Blautia属和 Dorea属 增加。关于肠道微生物群对炎症性中枢神经系统病理学影响的更多数据已从多发性硬化症动物模型研究中获得。这些数据支持这样的观点,即肠道微生物群失调正在积极促进多发性硬化症的发生和进展。
▼
糖尿病
研究发现,Haemophilus的丰度在糖尿病患者粪便中发生了改变。另人意外的是,研究显示Haemophilus的减少与2型糖尿病的发展相关。Haemophilus可能通过与免疫系统的相互作用影响糖尿病的发展。一些研究发现,Haemophilus的存在与自身抗体水平的负相关性,这可能意味着Haemophilus的减少可能导致免疫系统的异常反应,从而增加糖尿病的风险。
另一项研究发现,布劳特氏菌属(Blautia)、嗜血杆菌属(Haemophilus)丰度与TIDM(I型糖尿病)自身抗体个数相关。Haemophilus可能与肠道菌群的变化相关,从而影响糖尿病的发展。
▼
心脏疾病
慢性心力衰竭(CHF)是指一种持续性心力衰竭状态,可以稳定、恶化或失代偿。
个别研究显示嗜血杆菌和克雷伯氏菌在CHF患者的粪便中显着富集,可能意味它们可能是CHF的粪便生物标志物。作者进一步分析了肠道微生物群与血清代谢组之间的相关性。发现志贺氏菌与生物胞素和核黄素呈负相关。而嗜血杆菌与α-乳糖、纤维二糖、异麦芽糖、乳糖、蜜二糖、蔗糖、海藻糖呈负相关。
缺血性心脏病(IHD)是全球范围内人类死亡的首要原因。近年来研究表明,人体肠道菌群通过影响氧化三甲胺(TMAO)、苯乙酰谷氨酰胺(PAGln)、三甲基-5-氨基戊酸等相关代谢产物来促进IHD的发生和发展。宁波大学附属第一医院发现IHD患者毛螺菌科(Lachnospiraceae)和瘤胃球菌科(Ruminococcaceae)显著减少。且对疾病亚组分析提示,IHD患者的肠道链球菌属(Streptococcus)、嗜血杆菌属(Haemophilus)丰度显著富集。
前面讲过链球菌属和嗜血杆菌属的互作,它们都能在人类的上呼吸系统中发现。但是这两种菌呈现竞争趋势,而在肠道中这两种菌同时富集,可能是与上呼吸道不一样的生态模式,他们致病的机理还需要进一步探究。
▼
免疫系统
Haemophilus参与免疫系统的互作有以下几个方面的机制和关联线索:
SLPI调节
SLPI是一种抗菌肽,它在呼吸道中的丰度受到感染的调节。研究发现,Haemophilus的存在与SLPI的丰度增加相关。SLPI的表达调节是呼吸道微生物群和呼吸道黏膜免疫系统之间维持稳态的关键机制之一。
Haemophilus与哮喘
研究发现,Haemophilus在上呼吸道中的存在与成年人免疫控制不佳相关。这表明Haemophilus诱发的免疫可能在哮喘的发病机制中起到一定的作用。
锌补充与Haemophilus
锌是胎儿免疫系统发育的重要因素。研究发现,锌补充在孕期对贫困孟加拉婴儿对结核病卡介苗和流感嗜血杆菌b型疫苗的免疫反应有影响。
Haemophilus与免疫系统防御
Haemophilus居住在上呼吸道和口腔的黏膜上。多种Haemophilus菌株,如流感嗜血杆菌和溶血性流感嗜血杆菌,可以对抗宿主免疫系统并引起人类疾病。研究发现,IgAN患者对Haemophilus parainfluenzae的IgA抗体明显增多。IgA是黏膜免疫稳态的重要介质。
▼
精神分裂症
一项研究(n=126)显示,与健康受试者相比,处于疾病不同阶段(急性与缓解期)的参与者的肠道细菌不平衡。嗜血杆菌丰度与精神分裂症阴性症状呈正相关(r = 0.303, P = 0.021),而粪球菌丰度与精神分裂症阴性症状呈负相关(r = - 0.285, P = 0.025)。这可以作为精神分裂症不同阶段的指标,也为精神分裂症的研究提供新的视角。
▼
肺 癌
一项研究基于 VFDB 数据库分析了食管鳞状细胞癌患者和肺癌患者中细菌的丰度和分布,嗜血杆菌的绝对丰度可以将肺癌与健康对照区分开来(P≤0.05),该研究为食管鳞癌和肺癌的鉴别提供了可能的方法,并为后续研究物种水平上潜在的人类病原体在癌症发生中的作用提供了数据支持。
▼
其 他
癫痫
少量研究显示特发性局灶性癫痫患者肠道菌群中的弯曲菌属、代尔夫特菌属、嗜血杆菌属、奈瑟菌属丰度显著增加,并且在10.6%的癫痫患者肠道中检测出梭杆菌门,而在对照组中未检出。
强直性脊柱炎
一项来自调查强直性脊柱炎患者(包括5名同时患有IBD的AS-IBD)、59名IBD患者和105名健康对照者中获取粪便和肠道活检样本。发现强直性脊柱炎疾病活动度指数(BASDAI评分)增加的强直性脊柱炎患者和粪便钙卫蛋白>100 μg/mg的IBD患者中观察到潜在致病性嗜血杆菌属的富集。
原发性胆管炎
肠道微生物群的变化会影响肠道和肝脏,它们通过所谓的“肠-肝轴”严格连接。原发性胆汁性胆管炎,也称为“原发性胆汁性肝硬化”。该病发病机制与肠道菌群失调有关,通过引起细菌性胆管炎,进而刺激促炎症机制,促进胆管细胞的纤维化和炎症。
一些研究报告显示,原发性胆管炎患者胆汁和粪便微生物组的改变以乳酸杆菌、梭杆菌和肠球菌的高丰度和低多样性为特征。原发性胆管炎患者还表现肠道内肠球菌属,罗氏菌属,梭菌属,链球菌属,嗜血杆菌属的过度生长。
桥本甲状腺炎
福建中医药大学附属人民医院89名参与的一项研究显示,游离三碘甲状腺原氨酸(FT3)调节的Romboutsia和Haemophilus可能促进桥本甲状腺炎的发展,而游离甲状腺素(FT4)调节的Faecalibacterium和Lachnospiraceae可能保护宿主。
检出案例
以下是疾病人群粪便样本中检出的嗜血杆菌,尤其流感嗜血杆菌,该菌是病原菌,过多可导致菌群紊乱,可引发呼吸道感染,肠道检出也常见于呼吸道感染或其他感染。


<来源:谷禾健康肠道菌群检测数据库>
04
耐药趋势与临床治疗
(参考自:梅斯医学)
✓
氨苄西林曾经是治疗流感嗜血杆菌感染的经典药物之一,但是据2017年CHINET细菌耐药监测结果显示,流感嗜血杆菌对氨苄西林的耐药率均近45%或以上。其原因与不合理使用了3、4代头孢菌素、碳青霉烯类等广谱抗菌药物存在较大的关联。
贵州省一项研究,共收集住院患者临床分离株196株。所有研究的分离株均为不可分型流感嗜血杆菌(NTHi)。
氨苄西林、头孢克洛、阿奇霉素的耐药率分别为71.4%(140/196)、36.7%(72/196)、34.2%(67/196)。40.3% (79/196) 的菌株为 β-内酰胺酶阳性、氨苄西林耐药 (BLPAR)。β-内酰胺酶产生和 PBP3 突变的普遍存在可能导致局部氨苄青霉素耐药率较高。
临床上经验性选择氨苄西林用于临床治疗存在一定的风险;监测结果还显示,流感嗜血杆菌对除甲氧苄啶-磺胺甲唑外的其他抗菌药物敏感率均近70%或以上。因此,在未获得准确的药敏试验结果前,要根据患者病情及本地区的流调数据进行选药。比如可以考虑大环内酯类抗生素(阿奇霉素)和第1、2代菌素类抗生素为经验性治疗药物。
我们查阅其他研究资料显示,对于感染住院患者,联合使用氨苄西林和氯霉素或单一头孢菌素如头孢呋辛、头孢噻肟或头孢曲松可能是有效治疗嗜血杆菌的方法。
此外,针对儿童的b型流感嗜血杆菌(Hib),疫苗接种是预防2月龄-5周岁儿童由b型流感嗜血杆菌引起的侵袭性感染(包括脑膜炎、肺炎、败血症、蜂窝组织炎、关节炎、会厌炎等)主要的措施。
注意:以上仅供交流,不做医学建议。
主要参考文献
Chatziparasidis G, Kantar A, Grimwood K. Pathogenesis of nontypeable Haemophilus influenzae infections in chronic suppurative lung disease. Pediatr Pulmonol. 2023 Jul;58(7):1849-1860. doi: 10.1002/ppul.26446. Epub 2023 May 3. PMID: 37133207.
Shaikh N, Hoberman A, Paradise JL, Rockette HE, Kurs-Lasky M, Martin JM. Association Between Nasopharyngeal Colonization and Clinical Outcome in Children With Acute Otitis Media. Pediatr Infect Dis J. 2023 Aug 1;42(8):e274-e277. doi: 10.1097/INF.0000000000003956. Epub 2023 Apr 26. PMID: 37171965.
Zhou Y, Wang Y, Cheng J, Zhao X, Liang Y, Wu J. Molecular epidemiology and antimicrobial resistance of Haemophilus influenzae in Guiyang, Guizhou, China. Front Public Health. 2022 Dec 1;10:947051. doi: 10.3389/fpubh.2022.947051. PMID: 36530676; PMCID: PMC9751421.
Zhu C, Zheng M, Ali U, Xia Q, Wang Z, Chenlong, Yao L, Chen Y, Yan J, Wang K, Chen J, Zhang X. Association Between Abundance of Haemophilus in the Gut Microbiota and Negative Symptoms of Schizophrenia. Front Psychiatry. 2021 Jul 30;12:685910. doi: 10.3389/fpsyt.2021.685910. PMID: 34393849; PMCID: PMC8362742.
Du X, Liu J, Xue Y, Kong X, Lv C, Li Z, Huang Y, Wang B. Alteration of gut microbial profile in patients with diabetic nephropathy. Endocrine. 2021 Jul;73(1):71-84. doi: 10.1007/s12020-021-02721-1. Epub 2021 Apr 27. PMID: 33905112.
Kasai C, Sugimoto K, Moritani I, Tanaka J, Oya Y, Inoue H, Tameda M, Shiraki K, Ito M, Takei Y, Takase K. Comparison of human gut microbiota in control subjects and patients with colorectal carcinoma in adenoma: Terminal restriction fragment length polymorphism and next-generation sequencing analyses. Oncol Rep. 2016 Jan;35(1):325-33. doi: 10.3892/or.2015.4398. Epub 2015 Nov 4. PMID: 26549775.
Nocera A, Nasrallah HA. The Association of the Gut Microbiota with Clinical Features in Schizophrenia. Behav Sci (Basel). 2022 Mar 25;12(4):89. doi: 10.3390/bs12040089. PMID: 35447661; PMCID: PMC9025473.




 本文介绍了嗜血杆菌属的生物学特性、代谢途径、与其他菌群的相互作用,以及与多种疾病的关联,如多发性硬化症、结直肠癌等。还提及了其耐药趋势,指出氨苄西林耐药率较高,建议根据病情和流调数据选药,Hib疫苗可预防相关感染。
本文介绍了嗜血杆菌属的生物学特性、代谢途径、与其他菌群的相互作用,以及与多种疾病的关联,如多发性硬化症、结直肠癌等。还提及了其耐药趋势,指出氨苄西林耐药率较高,建议根据病情和流调数据选药,Hib疫苗可预防相关感染。


















 被折叠的 条评论
为什么被折叠?
被折叠的 条评论
为什么被折叠?










